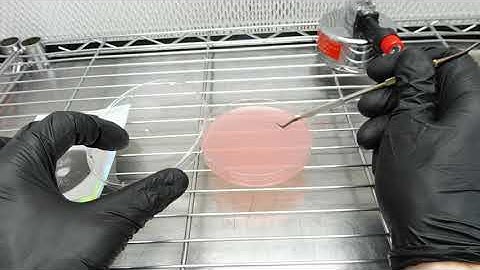
Spore Print to Agar

⬇ DOWNLOAD NOW
Jika muncul iklan pop-up, tutup lalu klik tombol kembali
Download lagu The Agar Files - Spore Print to Agar (Intro to Agar) secara gratis hanya untuk keperluan promosi. Dukung artis favorit kamu dengan membeli musik original di iTunes atau platform resmi lainnya.
 Spore Syringe to Agar - The Agar Files
Spore Syringe to Agar - The Agar Files Sporeswabs on Agar - The Agar Files
Sporeswabs on Agar - The Agar Files Spores to Agar Progress ( Time-lapse )
Spores to Agar Progress ( Time-lapse ) Spore Print to Agar
Spore Print to Agar Making a spore print for dummies! 30sec video to start your magic journey to mushrooms!
Making a spore print for dummies! 30sec video to start your magic journey to mushrooms! Spore Print to Agar ( Successful)
Spore Print to Agar ( Successful) The Agar Files - Making Transfers on Agar
The Agar Files - Making Transfers on Agar From Spore Print to Agar: Mushroom Cultivation At Home | DIY Mycology
From Spore Print to Agar: Mushroom Cultivation At Home | DIY Mycology